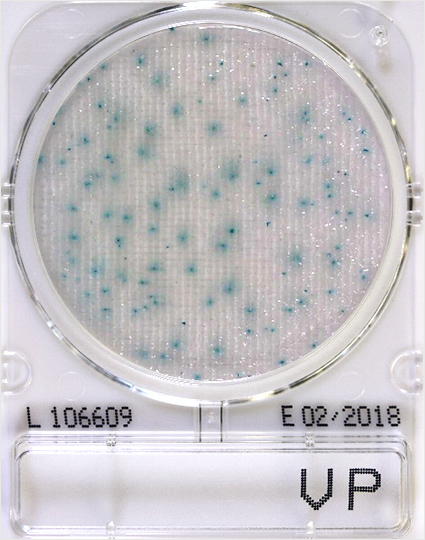
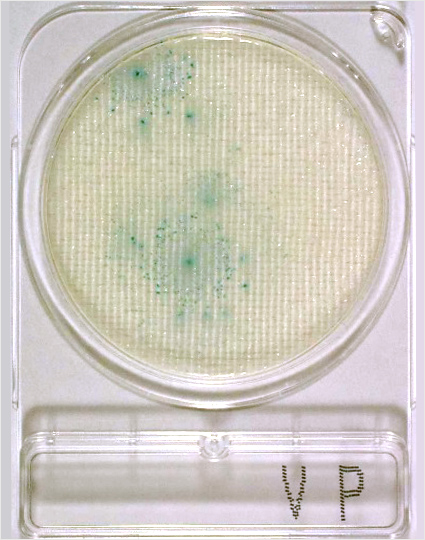
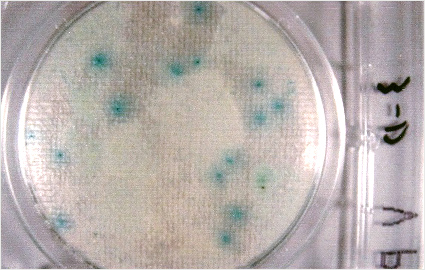
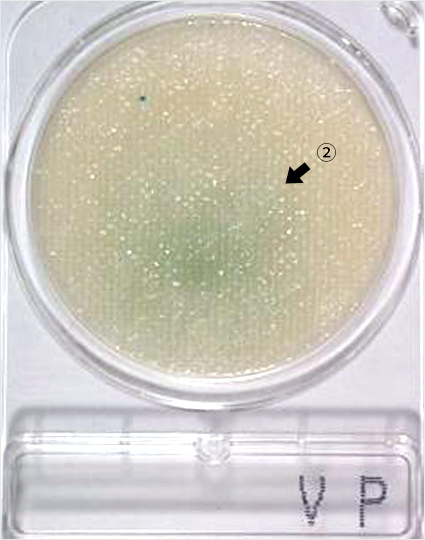
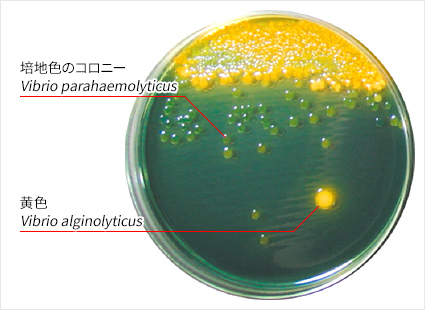
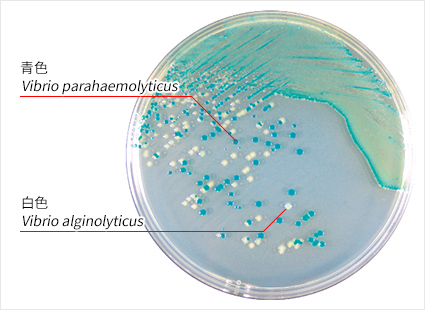

コンパクトドライ™ 判定ガイドコンパクトドライ™ VP
本ガイドは、コンパクトドライ™ VPの培養結果について適切に理解していただくためのものです。その他の製品については以下をご参照ください。
コンパクトドライ™ VP
| 用途 | 腸炎ビブリオ測定用 |
|---|---|
| VP | Vibrio parahaemolyticus |
| 特長 | ・コロニーが発色するので、測定が簡単 |
| 判定方法 | 培養温度 35±1℃ 培養時間 19±1時間 腸炎ビブリオ:青色コロニー |
生食用鮮魚介類や加熱魚介類製品は、その成分規格に腸炎ビブリオの試験法および基準が以下のように定められています。
・生食用鮮魚介類:MPNによる定量法で100以下
・加熱魚介類製品:増菌培養後の定性試験において陰性
これら成分規格に加え、加工に使用する水や海水、製造場所や小売場所についても製品への二次汚染を防ぐための検査を行うことが推奨されています。
純培養菌;腸炎ビブリオ(Vibrio parahaemolyticus)のコロニー性状
腸炎ビブリオは、シート表面に拡散したコロニーを形成することが多いため、青色の発色が濃い部分をコロニーの中心部とみなし、1個としてカウントしてください。

約40コロニー
2コロニー

3コロニー
腸炎ビブリオ以外
白色コロニーを形成。本菌は自然界で腸炎ビブリオと共存することが知られています。

いろいろな検体の培養例(陽性例)
腸炎ビブリオを検出した検体(ハマグリ)の培養例
青いコロニーと白色の広がったコロニーが観察されます。
腸炎ビブリオ(Vibrio parahaemolyticus)は中心部が比較的強い青色発色で、かつ周辺にやや拡散したコロニーを形成することが多いです。
腸炎ビブリオ陽性例
青色コロニーが多いため、全体に青が広がっています。
増菌培養した培養液を接種すると全体に青色が広がります。

いろいろな検体の培養例(陰性例)
ホッキ貝およびダルマイカのコンパクトドライ上に見られるやや扁平状で薄青コロニーを釣菌して同定したところ、腸炎ビブリオ以外の菌と同定されました。



無色たらこの(生食用)の青色で拡散していない締まったコロニーは、大腸菌群のなかまであるEnterobacter cloacaeと同定されました。
生するめいかの中心の薄く広く拡散した青色コロニーは、腸炎ビブリオ以外の海水ビブリオと同定されました。
大腸菌群、腸球菌、ブドウ球菌などの腸炎ビブリオ以外の菌種においても103 CFU/mL程度の高濃度の菌が接種された場合、青色コロニーを形成することがあります。これらの菌種はピンポイント状の青色コロニーや、周辺不定形で扁平状の青色コロニーを形成することが多いです。
関連製品
※コンパクトドライで疑わしいコロニーが得られた場合は公定法で再検査するか、公定法で用いられる寒天培地で再分離し、同定・鑑別を行ってください。